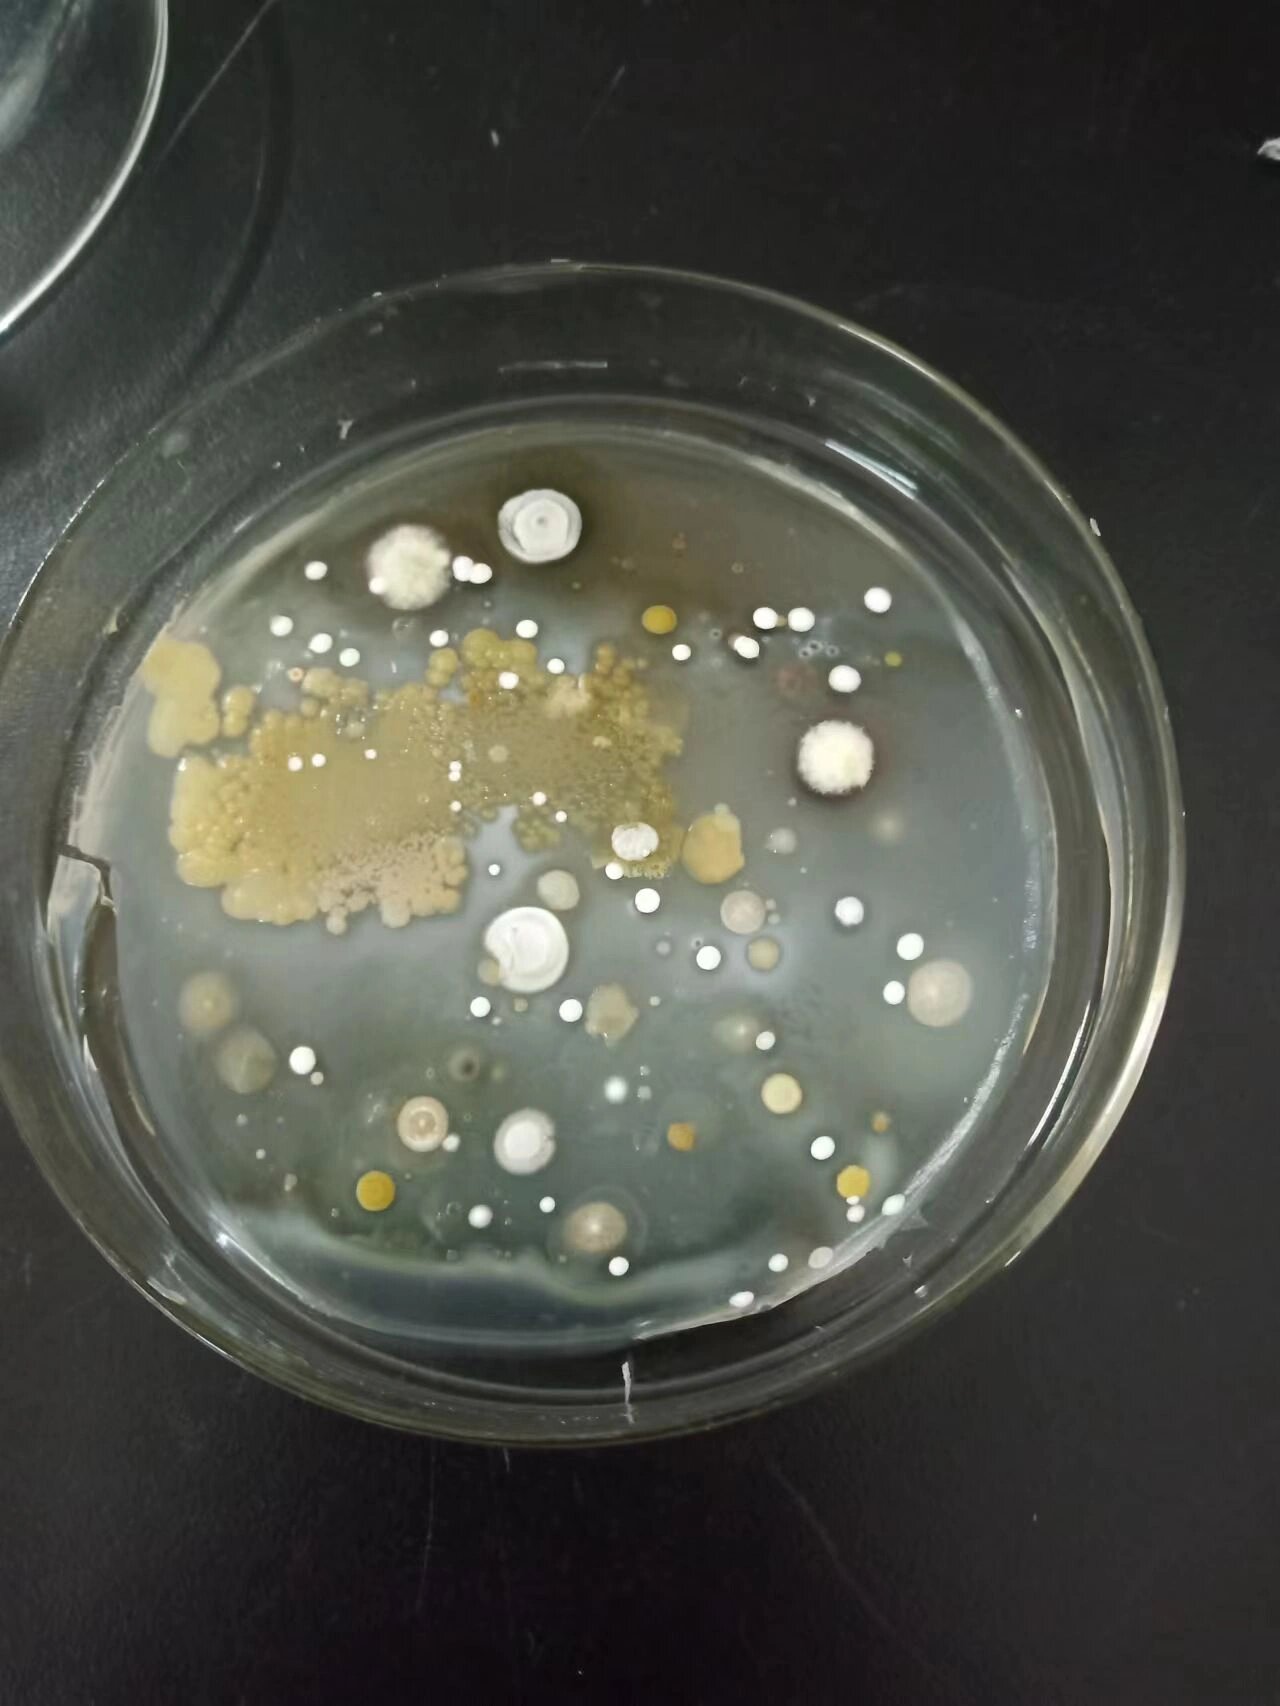
图二高氏一号培养基——放线菌 图三牛肉膏蛋白胨培养基——细菌 都

放线菌铅笔图

放线菌是由不同长短的纤细的菌丝所形成的单细胞菌丝体.
图片尺寸1536x2048
微生物实验红蓝铅笔图 细菌基本形态和特殊结构 金黄色葡萄球菌
图片尺寸960x1280
梭菌99白色念珠菌99肉毒梭菌99曲霉99#医学生 #红蓝铅笔绘图
图片尺寸1080x1439
放线菌简笔画
图片尺寸500x375
红蓝铅笔手绘微生物实验报告
图片尺寸1080x1428
医学生的作业存档—微生物手绘图
图片尺寸1536x2048
德干高原游动放线菌
图片尺寸686x692
放线菌属
图片尺寸1633x1723
p>放线菌( i>actinomycetes /i>)是原核生物中一类能形成分枝菌丝和
图片尺寸900x631
放线菌是由不同长短的纤细的菌丝所形成的单细胞菌丝体.
图片尺寸2048x1536
实验八四体,放线菌,真菌
图片尺寸421x466
放线菌有何特征?怎样防治?
图片尺寸637x823
环境微生物之放线菌
图片尺寸1000x834
放线菌
图片尺寸670x503
放线菌简笔画
图片尺寸500x375
放线菌
图片尺寸370x217
部分红树林放线菌形态图.受访者提供
图片尺寸550x554
图二高氏一号培养基——放线菌 图三牛肉膏蛋白胨培养基——细菌 都
图片尺寸1280x1706
菌鞭毛芽孢荚膜#医学微生物学#红蓝铅笔绘图#医学生绘图#医学生学习
图片尺寸1080x1437
放线菌的形态
图片尺寸640x485